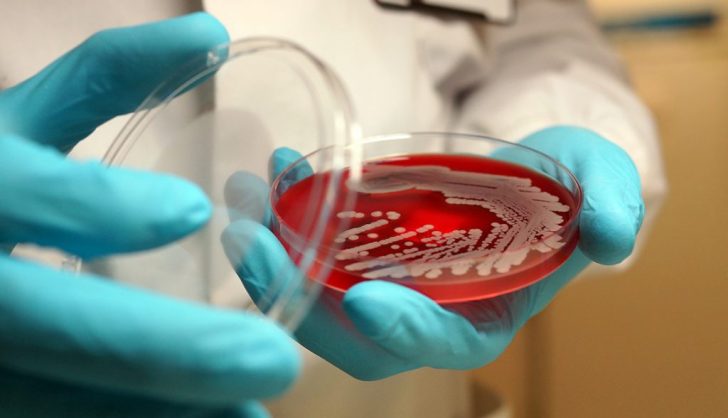
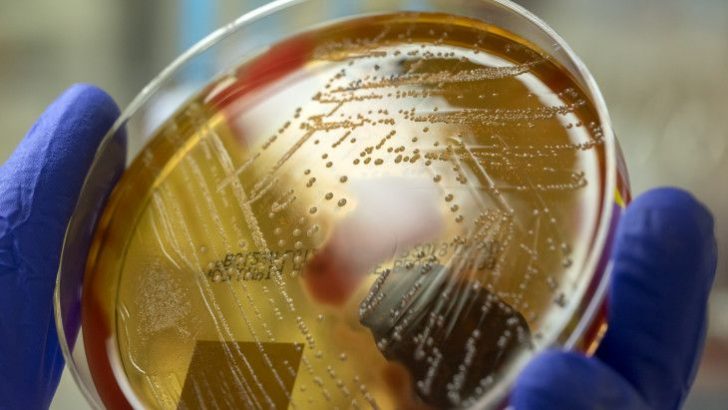

Researchers Use AI to Discover Compound That Kills Drug-Resisting Bacterium
Drug resistance is now becoming a significant threat to the public health industry. It is daunting to admit that the drugs we once believed to be effective are now becoming ineffective due to the emergence of drug-resistant bacteria. Acinetobacter baumannii, in particular, is dangerous and challenging to treat because most antibiotics are ineffective against it.
Researchers at MIT and McMaster University have now discovered a new antibiotic named Abaucin. Essentially, it is a newly discovered compound that can kill this drug-resistant bacterium – all thanks to artificial intelligence.
Elle | Thanks to the development in AI, the compound called ‘Abaucin,’ can kill Acinetobacter baumannii.
The Rise of Acinetobacter Baumannii
Acinetobacter baumannii is a bacterium that usually lives in the human body. However, it can also be found in hospital settings, especially if the location is improperly sanitized. It can cause various infections, such as pneumonia, meningitis, and urinary tract infections, that can lead to severe complications and death.
What makes A. baumannii a severe threat is the drug resistance it has developed against many antibiotics. It is becoming more common in hospitals worldwide, creating a crisis for medical professionals who are running out of options.
The Discovery of Abaucin
MIT and McMaster University researchers, in collaboration with a team of scientists from the AI firm, Atomwise, used machine learning to identify new compounds that can kill A. baumannii. The researchers inputted various data related to known antibiotics into the software, allowing the algorithm to create its model of what molecular structures might be effective in targeting A. baumannii.
GTN | Essentially, Acinetobacter baumannii – AKA A. baumannii – is a deadly bacterium that resists all existing drugs.
Afterward, the team screened 6,000 compounds, which led them to identify Abaucin. They tested the compound against A. baumannii strain variants, and the results were impressive. Abaucin successfully managed to kill all existing A. baumannii variants with minimal impact on human cells. As a result, it has been dubbed the ‘jackpot’ discovery.
Benefits of Abaucin
With A. baumannii becoming increasingly prevalent globally, medical professionals need new treatment options as older antibiotics are losing their efficacy. And this is where the discovery of Abaucin is significant. It presents medical professionals with an opportunity to curb the spread of A. baumannii.
In comparison to traditional antibiotic discovery methods, the advantage of using machine learning lies in its speed, accuracy, and ability to learn from large datasets. Thus, it is a promising technology for discovering new drugs and expanding the application of old ones.

Anna / Pexels | According to MIT researchers, Abaucin can potentially kill Acinetobacter baumannii – a deadly drug-resisting bacterium.
Challenges in Developing Abaucin
Despite the exciting prospect of using Abaucin as a treatment option for A. baumannii, there is still work to do in optimizing its production. Since the molecule is prevalent in plants, the researchers must determine the best way to extract it from the plants via a cost-effective, scalable process.
However, it is pertinent to note that this work is still in progress. And MIT researchers are exploring various methods. That is why these researchers are pretty optimistic that with the help of AI, they will be able to come up with more discoveries.